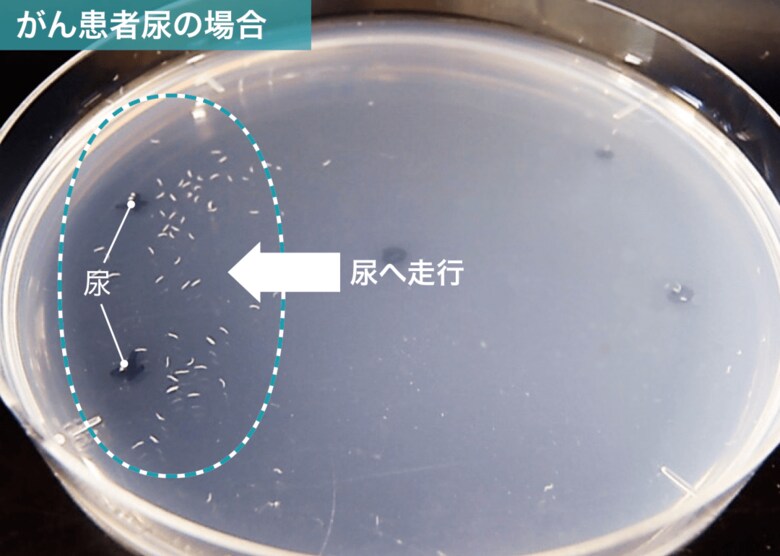
がん患者の尿に対しては匂いを感知した線虫が寄っていく

がんの早期発見に、線虫の嗅覚を活用
人生100年時代を迎えるなか、非常に身近な病気であり、誰にとっても他人事ではないがん。国立がん研究センターなどのデータによれば、日本人の約50%が一生のうちに一度はがんに罹患すると推計されている。
もっとも、「がん=死の病」というわけでは必ずしもない。がんの進行の初期段階で発見できれば、それだけ治癒の可能性が高まる。そこでカギとなるのは、早期発見と早期治療だ。ただし、初期段階では自覚症状がほとんどないことも多い。いざ身体の不調を感じ精密検査してみたら、かなり進行段階のがんが見つかったという話を、身の回りで耳にしたことのある方も少なくないだろう。とはいえ、がん検診は一般的にハードルが高く、身体的にも経済的にも大きな負担を伴うという課題もあった。
2016年創業のHIROTSUバイオサイエンスは、この社会課題に「がん特有の匂いを線虫で検知する」というアプローチで向き合ってきたバイオベンチャーだ。同社を率いる広津崇亮は、「線虫」研究の第一人者。体長1mmほどの線虫には、犬にも匹敵するといわれる「嗅覚」があることに着目し、その力を活かしてがんの匂いを感知する新しい検査法を発明するに至った。「微量な匂い物質を検出するという点において、機械ではなく生物の嗅覚を使うことで機械を上回る高精度を実現でき、飼育や解析に大きなコストがかからない線虫を用いれば、検査費用を抑えることもできるはず」――これが広津の発想の原点だ。
続いて広津たちが取り組んだのは、発明した技術の信頼性を科学的に証明すること。そのため、創業から最初の4年間は実際のサービス提供はせず、臨床研究に専念した。「その結果、得られた成果は論文として、世界中の学術誌に多数掲載され、厳しい査読を経て、国際的にも高く評価されるまでになりました。現在も、自社での研究開発に加え、30以上の国内外の医療機関や大学と連携し、共同研究を続けています」と、広津は振り返る。

次の10年へ向け、更なる挑戦が続く
4年間の研究開発を経て、線虫がん検査技術は「N-NOSE(エヌノーズ)」という名称で世に出た。少量の尿を提出するだけで、全身23種類(サービス開始当初は15種類)のがんリスクを網羅的かつ簡便に調べることができるサービスだ。病院に行かずとも、自宅で採尿して郵送するか指定薬局等に持ち込むだけで検査できる。全身を対象とする専門的ながん検査は数十万円以上かかることもあるが、N-NOSEは1万円代から検査可能だ。
こうした手軽さも支持され、N-NOSEの利用者は2025年3月段階で80万人を突破している。研究開発もさらに進み、特定のがん種の匂いにのみ特異的な反応を示す 「特殊線虫」を用いてがん種ごとのリスクを判定する「N-NOSE plus」も登場した。さらには人間同様に尿サンプルから複数のがんのリスクを判定できる「N-NOSE わんちゃん」(愛犬用)「N-NOSE ねこちゃん」(愛猫用)の提供も開始している。
広津は、「手の届きやすい価格設定であること、そして実社会での活用を通じて蓄積されたデータによる高い信頼性も、大きな特長です。この10年間の歩みと努力が、今のN-NOSEの信頼の基礎となっていると確信しています」と胸を張る。そんなN-NOSEの着想から10年。HIROTSUバイオサイエンスでは、社会に対する感謝の気持ちと、より多くの方にこの技術を届けたいという思いを込めて、「N-NOSE発明10年記念 大感謝祭」も実施中だ。
「病気になってから治す」医療から、「病気になる前に気づく」予防医学や未病への対応へ。創業以来変わらない、「がんが早期発見できる世界を作り、人々の健康と未来の安心を守りたい」という志を胸に、広津とN-NOSEの挑戦は続く。
問い合わせ先/線虫がん検査N-NOSE
https://lp.n-nose.com/